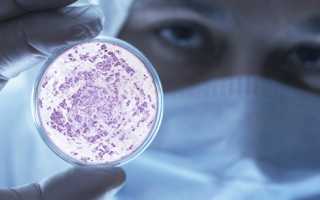

Кишечная палочка – Escherichia coli (E.Coli) – бактерия, состоящая из патогенных и непатогенных видов. Патогенные – основа возникновения инфекционно-воспалительных болезней пищеварения, половых и мочевыделительных органов мужчин и женщин. Непатогенные живут во взаимодействии с микрофлорой кишечника.
Разновидности
Распространённая бактерия патогенного вида – гемолитическая кишечная палочка. Последствия бактерий – от серьёзного отравления до развития дисбактериоза, колибактериоза. Часто палочки становятся виновниками болезней – воспаление мочевого канала, яичек, влагалища, лёгких; гнойное заражение головного мозга, крови.
Лактозонегативная палочка Эшериха – условно-патогенный микроорганизм. В кишечнике долго не определяется. При увеличении концентрации – проявляется болезнь.
Гемолитическая палочка у грудного ребёнка – причина смерти при отсутствии своевременной помощи.
Причины болезни
Заражение палочкой Эшериха передаётся фекально-оральным путём.
- употребление немытых овощей, фруктов, некипячёных жидкостей;
- нарушение санитарных правил, норм.
Основная группа, подвергаемая риску заражения – дети.
Гемолизирующая палочка у взрослых появляется при имуннодефиците, ОРЗ, приёме антибиотиков.
Кишечная палочка у женщин
Палочка Эшериха в кишечнике провоцирует инфекции в организме, но, являясь доброкачественными, они проходят в 7-10 дневной период. Заражения не вызывают усугублений, не являются причиной хронических болезней.
Опасайтесь заражения мочеполовых органов. Источник – кишечная бактерия.
Из-за высокого содержания в кале кишечных палочек они попадают в мочу и половые органы.
Способы попадания инфекции в уретру и влагалище:
- Отсутствие гигиены (промежность половых органов нерегулярно промывается, сохраняются остатки каловых масс).
- Используется облегающее нижнее бельё (половые органы потеют, остатки фекальных масс смещаются, попадая во влагалище).
- Ошибочная очерёдность подмывания (задний проход подмывается первым, затем моются половые органы).
- Анальные половые акты с мужчиной, в сперме которого завелась кишечная инфекция.
Воспаление половых органов женщин, из-за действия палочки, длится долго, трудно лечится.
Нередко в кишечнике происходит процесс воспаления, но симптомы проявляются незаметно: женщина считает себя здоровой, хроническая инфекция не выдаёт себя.
Стрессовая ситуация – сигнал к проявлению воспаления. Обострения болезни связаны с ношением палочки Эшериха.
Кишечная палочка у мужчин
Кишечные палочки у мужчин поражают половые органы, служат источником воспаления кишечника. В течение 10 дней патогенные бактерии проходят самостоятельно.
Воспалительные процессы, поражающие мочеполовые органы, меняют сексуальную и мочевыделительную функции.
Причина – проникновение палочки в уретру: возникает острый уретрит, симптомы исчезают через несколько суток, болезнь переходит в затяжную фазу. Бактерии поражают мочеиспускательный канал, дают осложнения на половые и мочевыделительные органы.
Следствие – мужской пол страдает простатитом, орхитом, эпидимитом. Более половины случаев хронического простатита у мужчин, достигших 35 лет и старше, обусловлено кишечной палочкой.
Оживление палочки Эшериха начнётся после переохлаждения, стрессовых ситуаций, служащих источником обострения простатита. Эти инфекции излечить трудно.
Став обладателем гемолизирующей бактерии, мужчина заражает женщин, становясь источником воспаления мочевого пузыря, заболевания почек и вагинит. Заражённая сперма поступает в вагину, результатом становится заражение половых органов партнёрш.
Палочка Эшериха у беременных
У беременных при анализе мочи иногда выявляют кишечную палочку, хотя ранее анализы патогенного микроба не наблюдали. Вывод – женщина давно носит бактерию, проявление вызвано ослаблением иммунной системы, не способной бороться с микробом.
Выявленный микроорганизм в анализах не свидетельствует о болезни, но показывает заражение мочеполовых органов палочкой, способной провоцировать воспалительный процесс.
Гинекологи назначают антибиотики, чтобы повысить иммунитет, избавиться от гемолизирующей кишечной палочки. Это провоцирует появление у беременной цистита, пиелонефрита.
Колибактерия небезопасна для новорожденного, заражённого при родах. Младенец болеет заражением крови, воспалением головного мозга и уха.
Лечат болезнь у беременных антибиотиками:
Антибиотик принимают в течение недели, после сдают анализ мочи. Через пару месяцев повторить процедуру на наличие бактерий; при отрицательном анализе недуг вылечен, при положительном – повторить лечение.
Кишечная бактерия у грудного ребёнка
У малыша кишечная палочка в кале представлена двумя формами – гемолитической и лактозонегативной.
При положительной пробе у ребёнка не стоит лечить инфекцию антибиотиками. Перед этим нужно провести внешний анализ.
Если малыш прибавляет в весе, не потерял аппетит, отсутствует водянистый стул при испражнении, лечения не потребуется.
При изменении общего состояния новорождённого, отсутствии какого-либо развития и наличии водянистого стула необходима терапия.
Симптомы
У взрослого населения кишечная инфекция похожа на сальмонеллёз:
- Появление тошноты, рвоты, наличие болей в животе.
- Повышение температуры.
- Запор, понос.
Период заболевания – 3-5 дней.
Гемолизированная палочка редко вызывает осложнения кишечника. Осложнения: заболевание почек, судорожное состояние, геморрагическая пурпура, парез, ригидность.
Сигналы кишечной палочки у малышей
У детей нет болезни, связанных с гемолитическими инфекционными палочками, ребёнок страдает от кишечного недуга.
Гемолизирующая кишечная палочка у детей является причиной ухудшения состояния. У малыша повышается жар организма, проявляется срыгивание и выходят рвотные массы. Частое хождение в туалет, проявляется понос.
При лёгком протекании недуга температура тела повышена и не достигает 38 градусов, хождение в туалет – не более 6 раз. При среднем протекании температура повышается до 39 градусов, стул – 12 раз. При обострении – жидкий стул до 15 раз в сутки, температура – 38-39 градусов.
У ребёнка с ослабленным иммунитетом палочка Эшериха проникает в кровеносные сосуды, поражает органы, вызывая гнойное воспаление, менингит, сепсис.
Гемолизирующая палочка у младенцев провоцирует повышенную температуру, мигрень, отсутствие аппетита. Самоизлечение – через 5-10 суток.
Лечение гемолизирующей кишечной палочки у взрослых
Лечение у взрослых начинают с исключения сигналов интоксикации.
Чтобы исключить риск обезвоживания организма, следует принимать регидратационные препараты. Рекомендуется щадящая диета, сопровождающаяся употреблением жидкости. Отказаться от жирного, солёного, газировки и спиртного.
Если гемолизирующая кишечная палочка у взрослых обнаружена в моче, это бактериурия. Терапия недуга включает приём антибиотиков, уросептиков, БАДов, укрепляющих иммунитет пациента и препятствующих развитию инфекционной болезни.
Если палочка Эшериха обнаружена в мочеполовых органах, начать приём антибиотиков, соблюдать гигиенические правила и временно отказаться от половых контактов.
Обнаруженная колибактерия у беременных и малышей лечится при помощи пробиотиков и вирусов, поражающих бактерии. В случае неудачи принимать антибиотики.
Повышенное содержание патогенных бактерий лечится использованием пребиотиков и пробиотиков. Эти медикаменты ускоряют регенерацию микрофлоры кишечника.
Народная медицина
Для эффективной защиты от недуга устоявшееся лечение комбинируют с нетрадиционным.
- 300 грамм топинамбура почистить, нарезать кубиками, молоко пополам с водой довести до кипения, закинуть нарезанное. Когда топинамбур станет мягким, вытащить, в узвар добавить 20 граммов муки, 40 граммов масла. Готовить до загустения. Приготовленным соусом облить топинамбур, украсить зеленью.
- Кипятить 25 г гусиной лапчатки в 300 мл жидкости. Готовить на пару в течение 20 минут, снять и оставить на 7-8 часов. Употреблять 70 мл трижды в сутки.
- 15 г череды перемешать с прохладной прокипевшей водой (четверть литра), готовить на пару в течение 20 минут. Принимать три раза в день по 20 мл.
- Смешать растения мать-и-мачеха, лекарственный донник, золототысячник для получения однородной массы (25 г). Влить 200 мл горячей воды, дать настояться 20 минут. Употреблять два раза в сутки по 20-50 мл.
- Соблюдать профилактические мероприятия:
- промывать фрукты и овощи перед употреблением;
- кипятить молочную продукцию;
- отказаться от воды из крана;
- перед приёмом пищи мыть руки с мылом.
Гемолитическая (гемолизирующая) кишечная палочка – это один из представителей условно-патогенной флоры человеческого организма. Обитает на слизистых оболочках пищеварительного канала, репродуктивной сферы мужчины и женщины, мочеполового тракта. Серьезные повреждения может нанести только в том случае, если организм человека находится в состоянии выраженного иммунодефицита.
Чем опасен возбудитель?

Важным моментом является не только количество гемолитической кишечной палочки, но и ее соотношение (процентное содержание) относительно других представителей нормальной микрофлоры человеческого организма. О серьезной опасности для человека любого возраста следует думать только в том случае, если развивается дисбактериоз – количество клеток условно-патогенной микрофлоры преобладает над нормальной (непатогенной).
Среди осложнений, которые может спровоцировать гемолизирующая кишечная палочка, выделяют:
- различные формы кишечной инфекции (гастрит, гастроэнтерит, гастроэнтероколит);
- воспаление мочеполового тракта (цистит, пиелит);
- поражение репродуктивной сферы (простатит у мужчин, сальпингоофорит у женщин).
Кроме того, возможно тяжелое течение кишечной инфекции, которое осложняется гиповолемическим или инфекционно-токсическим шоком.
Пути заражения
О преимущественном пути передачи в данном случае говорить не совсем целесообразно, так как гемолизирующая кишечная палочка находится везде и избежать контакта с ней и последующего инфицирования невозможно. Организм ежедневно атакует множество микробных агентов, но этого не нужно бояться, так как иммунная система оперативно распознает патогенны и адекватно на них реагирует.
Попадание гемолитической кишечной палочки внутрь человеческого организма возможно следующими путями:
контактно-бытовым – при несоблюдении элементарных правил личной гигиены, использовании неправильно обработанных или вообще необработанных предметов обихода с другим инфицированным человеком (посуда, белье, полотенца, детские игрушки);
- пищевым – при употреблении контаминированных (зараженных этой кишечной палочкой) овощей, ягод и фруктов, а также других кулинарных блюд, которые не прошли термическую обработку;
- водным – при употреблении недостаточно очищенной воды для питья, бытовых целей, а также при купании в водоемах, не предназначенных для купания.
Еще раз подчеркиваем, что инфицирование гемолизирующей кишечной палочкой только в редких случаях приводит к развитию клинически манифестных форм заболевания.
Рост и размножение бактерии
Росту и размножения этой бактерии способствует все, что ослабляет защитные силы организма:
- несбалансированное питание;
- пренебрежение личной гигиеной (особенно интимной);
- беспорядочные половые контакты;
- отсутствие адекватного лечения острых инфекционных заболеваний;
- несоблюдение правил профилактики рецидивов хронической патологии.
Все, что входит в понятие здорового образа жизни, подавляет или замедляет рост патогенной кишечной палочки.
Варианты проявления симптомов
Клинической симптоматики, характерной только для гемолитической кишечной палочки, нет. Подтвердить приоритетную роль именно этого микробного агента как главной причины заболевания можно только в результате лабораторного обследования.
Все варианты клинической симптоматики можно несколько условно разделить на местные и общие.

- повышение температуры тела до невысоких значений (обычно не выше 38 °С);
- слабость, повышенная утомляемость;
- снижение работоспособности, чрезмерная немотивированная сонливость.
По этим признакам можно только заподозрить системное заболевание, но не установить его причину.
Так же как и системные изменения, характеризуются неспецифичностью и полиморфностью. Удобно рассматривать возможные клинические признаки в соответствии с преимущественной локализацией бактерии.
| Локализация бактерии | Местная симптоматика |
| Желудочно-кишечный тракт |
|
| Мочевыделительная система |
|
| Репродуктивная сфера |
|
Оценить выраженность всех признаков, подтвердить этиологию патологического процесса и оценить необходимость элиминации гемолизирующей кишечной палочки может только врач.
Особенностей течения заболевания, вызванного данным микроорганизмом, у детей обычно не наблюдается. Следует отметить, что у детей до 3-х лет, в более короткие сроки развиваются осложнения: гиповолемический или инфекционно-токсический шок.
Лечение
Терапия необходима только в случае выраженной клинической симптоматики, а также подтверждения этиологии заболевания. Если в анализах кала на дисбактериоз обнаружена гемолизирующая палочка, то этот факт не является основанием для применения антибиотиков и других медикаментов. Это касается как взрослых, так и детей.
Профилактика
Целесообразно говорить о профилактике, если речь идет о возможном развитии заболевания, вызванного патогенной микрофлорой. В этом случае следует говорить о соотношении условно-патогенной флоры и возможности ее активации. Поэтому вполне достаточно соблюдать принципы здорового образа жизни:
Это поможет избежать увеличения количества гемолитической кишечной палочки и предупредить возможное заболевание.
В кишечнике обитает большое количество различных микроорганизмов. Они регулируют пищеварительные процессы и усвоение пищи. Многие из них – это условно-патогенные микроорганизмы.
Это значит, что в умеренных количествах они не причиняют вреда, но под влиянием определенных факторов эти микроорганизмы начинают активно размножаться, вызывая заболевание. Одной из них является гемолитическая кишечная палочка.
Это граммотрицательная бактерия, устойчивая к воздействию лекарственных препаратов и иммунной системы. Микроорганизмы долго сохраняют свою жизнеспособность в воде, каловых массах, почве. Под влиянием прямых солнечных лучей, кипячения, дезинфекции гемолизированная палочка погибает.
Активное размножение этой бактерии вызывает неприятные симптомы. Больные жалуются на вздутие живота и повышенное газоотделение. Запоры могут приходить на смену диарее. В каловых массах присутствует большое количество слизи и гнойного содержимого, напоминающего гной. Основной путь передачи инфекции – фекально-оральный способ.
Источником заражения являются люди со стертой формой эшерихиоза. В большинстве случаев подобного рода нарушения встречаются в детском возрасте. Спровоцировать его может банальное переохлаждение, простуда, ОРВИ, грипп, неправильное питание, ослабленный иммунитет и другое.
В итоге бактерия образует целые колонии в просвете тонкого и толстого кишечника, а также на слизистых оболочках мочевыделительных органов. Лечение нарушения включает в себя прием биологически активных добавок с высоким содержанием полезных микроорганизмов и коррекцию рациона питания.
Прежде чем подробнее рассматривать особенности методов борьбы, поговорим о том, что представляет собой эта бактерия и как проявляется клинически ее активное размножение.
Чаще нарушение возникает у детей. У грудничков гемолитическая кишечная палочка может даже стать причиной смерти
Разновидности
Разновидностей эшерихий существует огромное множество, но специалисты объединяют их в четыре основные группы:
- Энтеротоксигенные. Они являются причиной диареи у новорожденных. Бактерии прилипают к внутренней оболочке тонкой кишки и провоцируют образование ядовитых веществ.
- Энтероинвазивные. Вызывают диарею с кровянистыми примесями и болью в животе.
- Энтеропатогенные. Способны вызвать рвоту, понос, болезненность. Появление заболевания связано с переменой климата.
- Энтерогеморрагические. Считаются наиболее опасным типом. Вызывают схваткообразные боли, повышенную температуру, диарею. Гемолитическая кишечная палочка относится именно к этой группе. Энтерогеморрагический тип способен вызвать гемолитическую анемию и нарушение функций почек.
Все вышеупомянутые типы эширихии отличаются выносливостью и умеют хорошо приспосабливаться к различным условиям окружающей среды. Молочные продукты являются благоприятной средой для активного размножения этих бактерий.
Причины
Заражение может произойти через употребление невымытых овощей, фруктов, некипяченой воды или молока. Недостаточная термическая обработка мясных продуктов и рукопожатие больного человека – это еще одни распространённые причины кишечных инфекций. Больше всего подвержены заболеванию дети. Нарушение санитарных норм повышает риски заражения.
Для того чтобы произошло заражение, необходимо проникновение большого количества бактерий. Наличие микроорганизмов в продуктах не влияет на их цвет, вкус, запах, поэтому при употреблении зараженной пищи человек ничего не подозревает.
Молочные продукты являются благоприятной средой для жизнедеятельности кишечной палочки
Случаи заболеваемости чаще всего фиксируются в теплый период года. Чаще всего источником заражения становятся такие блюда:
- мясо и рыба;
- молочные продукты;
- соусы, салаты;
- крема, кондитерские изделия.
Часто заболевание развивается на фоне ослабленного иммунитета. Бесконтрольный прием антибиотиков, респираторные заболевания, переохлаждение – все это может ослабить резистентность организма. Токсины гемолитической палочки провоцируют воспалительный процесс и структурные изменения в кишечнике. Наряду с этим, развиваются общие симптомы интоксикации организма.
Симптомы
Период от заражения до появления первых клинических симптомов длится от трех до шести дней. Проникновение инфекционного агента стимулирует появление симптомов гастроэнтерита:
- болезненность в области эпигастрии;
- тошнота;
- ощущение тяжести в животе;
- рвота;
- понос;
- головная боль и головокружение;
- незначительное повышение температуры;
- ухудшение аппетита;
- слабость и снижение работоспособности;
- обезвоживание организма.
В тяжелых случаях наблюдается артериальная гипотония, бледность и синюшность кожных покровов, судороги, шоковое состояние. Кишечная инфекция вызывает схваткообразные боли в животе
Гемолизирующая кишечная палочка у взрослых
Для начала поговорим о том, как заболевание проявляется у женщин. Патогенные микроорганизмы способны проникнуть в мочеполовую систему. Причинами этому могут быть:
Боль в животе и температура
- недостаточное соблюдение правил интимной гигиены;
- ношение сдавливающего синтетического белья. Это создает парниковый эффект. Остатки фекалий могут смещаться и проникать во влагалище;
- неправильное подмывание. Не сверху вниз, а из стороны анального прохода к половым органам;
- анальный секс.
Что касается мужчин, то кишечная палочка часто проникает в мочеиспускательный канал. Бактерии поражают уретру, давая осложнения на половые органы и мочевыделительную систему. Согласно статистике, более половины случаев хронического простатита обусловлено именно воздействием кишечной палочки.
Особенности развития инфекции у детей
Желудочно-кишечный тракт новорожденного ребенка абсолютно стерилен. Лишь со временем бактериальная микрофлора населяет кишечник. У малыша появляется вздутие живота, боли в животике, развивается диатез. Каловые массы приобретают жидкую или кашицеобразную консистенцию с неприятным запахом. Стул становится пенистым с зеленоватым оттенком.
Нарушение хранения молочных продуктов или зараженное грудное молоко может стать причиной заражения
Кишечная инфекция вызывает обезвоживание организма, которое проявляется в виде следующих симптомов:
- сухость кожи и слизистых оболочек;
- появление складок на коже;
- плач, который не сопровождается выделением слезной жидкости;
- редкое мочеиспускание.
Ребенок часто срыгивает, диарея сменяется запором. Кишечные колики усиливаются при кормлении. Ребенок начинает отказываться от еды, капризничает. Состояние требует незамедлительной помощи, так ребенок может из-за этого погибнуть.
Новорожденные могут заразиться от матери. Неправильное питание, нарушения со стороны ЖКТ, слабый иммунитет – все это может привести к заражению. Ребенку назначают пребиотики и пробиотики. Первая группа лекарственных средств не содержит в своем составе полезных бактерий, но в их составе имеются вещества, которые стимулируют развитие популяции микроорганизмов.
Популярными представителями пребиотиков является Хилак-форте и Дюфалак. Если говорить о пробиотиках, то они отличаются наличием в своем составе подготовленных культур полезных бактерий. Для борьбы с обезвоживанием и восполнением потери жидкости назначаются регидратационные растворы.
Вывести из организма токсические вещества способны энтеросорбирующие средства. Наряду с этим, матери следует также соблюдать диетическое питание. Рекомендовано употреблять плоды и отвар чернослива. Прекращать грудное вскармливание не стоит.
Материнское молоко содержит лактозу, которая поможет нормализовать процессы пищеварения и населить кишечник полезными микроорганизмами. Если же ребенок находится на искусственном вскармливании, тогда лучше отдавать предпочтение смесям с пребиотиками. Их использование следует согласовывать с врачом.
Грудное молоко поможет справиться с кишечной инфекцией
Осложнения
У взрослых кишечная инфекция распространяется на мочеполовую систему и вызывает воспалительный процесс. Бактерия является распространённой причиной цистита и пиелонефрита. У женщин часто развиваются воспалительные процессы придатков матки, а у мужчин – простатит.
У людей преклонного возраста, чей организм ослаблен хроническими инфекциями, возможно развитие таких осложнений:
- сердечная недостаточность;
- тромбоз;
- заражение крови;
- инфекционно-токсический шок;
- гиповолемический шок.
Кишечная палочка также способна вызвать гемолитико-уремический синдром. Он развивается на фоне ослабленного иммунитета. Бактерия разрушает стенки капилляров и нарушает микроциркуляцию крови.
Заподозрить развитие гемолитико-уремического синдрома можно по таким признакам: наличие крови в каловых массах, высокая температура, кровоизлияния, воспаление толстого кишечника, тромбоз сосудов, некроз мелких сосудов, почечная недостаточность.
Ослабленный иммунитет становится распространенной причиной развития осложнений
Особенности диагностики и лечения
Бактериологическое исследование поможет обнаружить и идентифицировать возбудителя заболевания. Для исследования берутся кал, рвотные массы, остатки пищи, промывные воды. Медикаментозное лечение назначается на основании результатов бактериологического анализа.
Для более быстрой диагностики подходит серологический метод. Для его проведения делается забор венозной крови. Наряду с этим, проводится общий анализ крови, мочи и кала. Лечебная тактика подбирается с учетом некоторых факторов:
- возраст пациента;
- общее состояние;
- клинические симптомы;
- сопутствующие заболевания;
- имеющиеся осложнения;
- реакция на медикаментозные средства.
Для подавления бактериальной инфекции назначаются антибиотики. Мощным спектром действия обладают антибактериальные средства из группы фторхинолоны: Ципрофлоксацин, Левофлоксацин. Эти средства малотоксичны, но при этом быстро проникают в ткани бактерии, приведя к их гибели. У кишечной палочки медленно развивается устойчивость к влиянию фторхинолонов.
Для борьбы с обезвоживанием следует выпивать до трех литров в сутки
Для восстановления водно-солевого баланса и компенсации потерянной жидкости врачи назначают регидратационные препараты: Орсоль, Регидрон, Орасан. В тяжелых случаях используют растворы для внутривенного вливания. Для борьбы с интоксикацией в организм вводится большое количество жидкости. С этой целью применяются солевые растворы и глюкоза.
Известными дезинтоксикационными средствами являются: hаствор Рингера, Дисоль, Маннитол.
Наряду с этим, назначается симптоматическое лечение, включающее в себя следующее:
- для очищения ЖКТ применяются энтеросорбенты: Полисорб, Смекта, Энтеросгель;
- при поносе назначают Имодиум, Лоперамид, Линекс;
- справиться с болью в животе поможет Но-шпа, Спазмалгон;
- нестероидные противовоспалительные средства купируют воспалительную реакцию: Ибупрофен, Диклофенак;
- восстановить микрофлору кишечника помогут эубиотики: Ацилакт, Бифидумбактерин;
- поливитаминные комплексы.
Наряду с медикаментозной терапией, важно соблюдать диетическое питание и питьевой режим. Ускорить процесс выздоровления помогут средства народной медицины. Почищенный и нарезанный кубиками топинамбур заливают водой и молоком, а затем доводят до кипения.
После того как топинамбур станет мягким, его вынимают, а в емкость добавляют небольшое количество муки и сливочного масла. Готовить следует до полного загустения. Полученным соусом поливают топинамбур и употребляют.
Гусиную лапчатку заливают водой и проваривают на водяной бане. Средство должно настояться всю ночь. Принимать следует три раза в день по 70 г. В равных пропорциях смешайте мать-и-мачеху, донник и золототысячник и залейте кипятком. Средство должно настояться в течение получаса. Отфильтрованный раствор принимают два раза в день по 50 г.
Если вы хотите предотвратить развитие кишечной инфекции, перед употреблением промывайте овощи и фрукты под проточной водой. Молочную продукцию обязательно кипятите. Откажитесь от употребления воды из-под крана. Не забывайте перед приемом пищи тщательно мыть руки с мылом.
Учитывая все вышесказанное, можно с уверенностью сказать, что гемолитическая кишечная палочка способна вызвать опасный воспалительный процесс, чреватый развитием опасных для жизни осложнений. Чаще всего кишечные инфекции диагностируются у детей.
Заразиться можно через невымытые руки и овощи, продукты, прошедшие недостаточную термическую обработку, даже рукопожатие с зараженным человеком может привести к развитию воспалительной реакции. Простые меры профилактики, включающие в себя соблюдение правил личной гигиены, помогут предотвратить заражение.
Читайте также:






 контактно-бытовым – при несоблюдении элементарных правил личной гигиены, использовании неправильно обработанных или вообще необработанных предметов обихода с другим инфицированным человеком (посуда, белье, полотенца, детские игрушки);
контактно-бытовым – при несоблюдении элементарных правил личной гигиены, использовании неправильно обработанных или вообще необработанных предметов обихода с другим инфицированным человеком (посуда, белье, полотенца, детские игрушки);